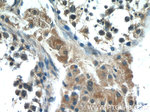
HIVEP1 Antibody in Immunohistochemistry (Paraffin) (IHC (P))
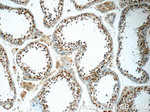
HIVEP1 Antibody in Immunohistochemistry (Paraffin) (IHC (P))

Search
Proteintech
HIVEP1 Polyclonal Antibody
{{$productOrderCtrl.translations['antibody.pdp.commerceCard.promotion.promotions']}}
{{$productOrderCtrl.translations['antibody.pdp.commerceCard.promotion.viewpromo']}}
{{$productOrderCtrl.translations['antibody.pdp.commerceCard.promotion.promocode']}}: {{promo.promoCode}} {{promo.promoTitle}} {{promo.promoDescription}}. {{$productOrderCtrl.translations['antibody.pdp.commerceCard.promotion.learnmore']}}
产品信息
25168-1-AP
种属反应
宿主/亚型
分类
类型
抗原
偶联物
形式
浓度
规格
纯化类型
保存液
内含物
保存条件
运输条件
产品详细信息
Immunogen sequence: TLQPTPGLP SPHTHLFSHL PLHSQQQSRT PYNMVPVGGI HVVPAGLTYS TFVPLQAGPV QLTIPAVSVV HRTLGTHRNT VTEVSGTTNP AGVAELSSVV PCIPIGQIRV PGLQNLSTPG LQSLPSLSME TVNIVGLANT NMAPQVHPPG LALNAVGLQV LTANPSSQSS PAPQAHIPGL QILNIALPTL IPSVSQVAVD AQGAPEMPAS QSKACETQPK QTSVASANQV SRTESPQGLP TVQRENAKKV LNPPAPAGDH ARLDGLSKMD TEKAASANHV KPKPELTSIQ GQPASTSQPL LKAHSEVFTK PSGQQTLSPD RQVPRPTALP RRQPTVHFSD VSSDDDEDRL VIAT (2366-2718 aa encoded by BC140816)
靶标信息
This gene encodes a transcription factor belonging to the ZAS family, members of which are large proteins that contain a ZAS domain - a modular protein structure consisting of a pair of C2H2 zinc fingers with an acidic-rich region and a serine/threonine-rich sequence. These proteins bind specifically to the DNA sequence motif, GGGACTTTCC, found in the enhancer elements of several viral promoters, including human immunodeficiency virus (HIV), and to related sequences found in the enhancer elements of a number of cellular promoters. This protein binds to this sequence motif, suggesting a role in the transcriptional regulation of both viral and cellular genes.
仅用于科研。不用于诊断过程。未经明确授权不得转售。
篇参考文献 (0)
生物信息学
蛋白别名: Cirhin interaction protein; CIRIP; DNA-binding protein; GAAP; Gate keeper of apoptosis-activating protein; HIV-EP1; human immunodeficiency virus type I enhancer binding protein 1; Human immunodeficiency virus type I enhancer-binding protein 1; major histocompatibility complex binding protein 1; Major histocompatibility complex-binding protein 1; MBP-1; positive regulatory domain II binding factor 1; Positive regulatory domain II-binding factor 1; PRDII-BF1; unnamed protein product; Zinc finger protein 40
基因别名: CIRIP; CRYBP1; GAAP; HIVEP1; MBP-1; PRDII-BF1; Schnurri-1; ZAS1; ZNF40; ZNF40A
UniProt ID: (Human) P15822
Entrez Gene ID: (Human) 3096